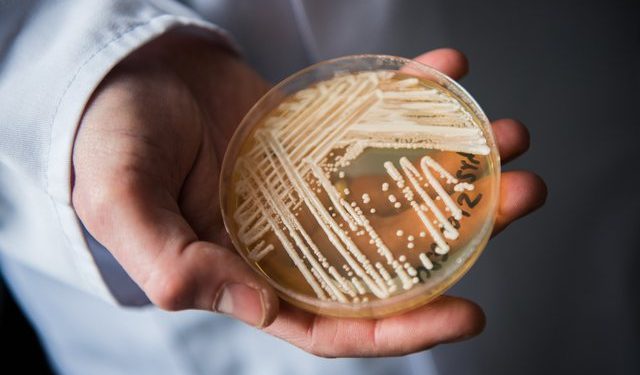

Një infeksion kërpudhat vdekjeprurës që është i vështirë për t’u trajtuar po përhapet me shpejtësi me një ritëm “alarmantë”, thotë Qendra për Kontrollin dhe Parandalimin e Sëmundjeve (CDC).
Rastet në SHBA gati u dyfishuan në vitin 2021 – nga 756 në 1,471, thotë raporti i CDC.
Njerëzit e shëndetshëm nuk janë në rrezik nga Candida auris, por ata me sistem imunitar të dobët – ose duke përdorur pajisje mjekësore si ventilatorë ose kateter – mund të vuajnë nga sëmundje të rënda ose të vdesin.
Shumica e rasteve të testuara ishin imun ndaj trajtimit anti-mykotik.
Për këtë arsye CDC e ka quajtur atë një “kërcënim urgjent të rezistencës antimikrobike”. Shumë pacientë janë në spitale dhe shtëpi të të moshuarve.
Ai mund të përhapet nga “kontakti me pacientët e prekur dhe sipërfaqet ose pajisjet e kontaminuara”, tha CDC.
Një në tre pacientë me infeksione invazive vdes, por mund të jetë e vështirë të vlerësohet roli i saktë që ka luajtur Candida auris në pacientët e cenueshëm, tha epidemiologia e CDC Dr Meghan Lyman, autorja kryesore e raportit.
Simptomat më të zakonshme janë ethet dhe të dridhurat që nuk përmirësohen pas trajtimit, sipas CDC.
Për shkak se shumica e pacientëve janë tashmë të sëmurë, ndonjëherë është e vështirë të zbulohet infeksioni fungal. Vetëm një test laboratorik mund të konfirmojë një infeksion.
Infeksioni u raportua për herë të parë në SHBA në vitin 2016. Rritja më e shpejtë e rasteve ishte nga viti 2020 deri në vitin 2021, sipas të dhënave të CDC të publikuara në Annals of Internal Medicine.
Një tjetër arsye shqetësuese ishte shtimi i rasteve që u bënë “rezistente ndaj ekinokandinave” që është ilaçi antimykotik më i rekomanduar për trajtimin e infeksionit.
CDC ia atribuon rritjen e numrit të rasteve të raportuara me parandalimin e dobët të infeksionit në institucionet e kujdesit shëndetësor, si dhe përpjekjet e zgjeruara të shqyrtimit që kanë rritur rritjen e infeksioneve, shkruan BBC.
Gjithashtu mund të jetë përkeqësuar për shkak të tendosjes në kujdesin shëndetësor dhe sistemet e shëndetit publik gjatë pandemisë Covid-19.
Në Misisipi, epidemiologu kryesor i shtetit ka identifikuar një strukturë afatgjatë të kujdesit akut që të jetë në qendër të shpërthimit.
“Fatkeqësisht, organizmat rezistent ndaj shumë ilaçeve si C. auris janë bërë më të përhapur në mesin e individëve tanë me rrezik më të lartë, siç janë banorët në objektet e kujdesit afatgjatë,” tha Dr Paul Byers për NBC.
Sipas të dhënave paraprake të CDC, kishte 5 raste klinike të Candida auris në vitin 2022. Në shtetet më të populluara si Kalifornia dhe Teksasi, kishte përkatësisht 359 dhe 160 raste.
Në mbarë vendin kishte 2,377 raste klinike në 2022, që do të ishte një rritje e dukshme nga 1,471 raste në 2021.
Dr Lyman, tha për CBS News se rritja “thekson nevojën për mbikëqyrje të vazhdueshme, kapacitet të zgjeruar laboratorik, teste më të shpejta diagnostikuese dhe respektimin e parandalimit dhe kontrollit të provuar të infeksionit”.
Vende të tjera gjithashtu kanë parë një rritje të rasteve të Candida auris.
Vitin e kaluar, Organizata Botërore e Shëndetësisë e përfshiu atë në listën e saj të “patogjenëve me përparësi fungale”.
Një infeksion kërpudhat vdekjeprurës që është i vështirë për t’u trajtuar po përhapet me shpejtësi me një ritëm “alarmantë”, thotë Qendra për Kontrollin dhe Parandalimin e Sëmundjeve (CDC).
Rastet në SHBA gati u dyfishuan në vitin 2021 – nga 756 në 1,471, thotë raporti i CDC.
Njerëzit e shëndetshëm nuk janë në rrezik nga Candida auris, por ata me sistem imunitar të dobët – ose duke përdorur pajisje mjekësore si ventilatorë ose kateter – mund të vuajnë nga sëmundje të rënda ose të vdesin.
Shumica e rasteve të testuara ishin imun ndaj trajtimit anti-mykotik.
Për këtë arsye CDC e ka quajtur atë një “kërcënim urgjent të rezistencës antimikrobike”. Shumë pacientë janë në spitale dhe shtëpi të të moshuarve.
Ai mund të përhapet nga “kontakti me pacientët e prekur dhe sipërfaqet ose pajisjet e kontaminuara”, tha CDC.
Një në tre pacientë me infeksione invazive vdes, por mund të jetë e vështirë të vlerësohet roli i saktë që ka luajtur Candida auris në pacientët e cenueshëm, tha epidemiologia e CDC Dr Meghan Lyman, autorja kryesore e raportit.
Simptomat më të zakonshme janë ethet dhe të dridhurat që nuk përmirësohen pas trajtimit, sipas CDC.
Për shkak se shumica e pacientëve janë tashmë të sëmurë, ndonjëherë është e vështirë të zbulohet infeksioni fungal. Vetëm një test laboratorik mund të konfirmojë një infeksion.
Infeksioni u raportua për herë të parë në SHBA në vitin 2016. Rritja më e shpejtë e rasteve ishte nga viti 2020 deri në vitin 2021, sipas të dhënave të CDC të publikuara në Annals of Internal Medicine.
Një tjetër arsye shqetësuese ishte shtimi i rasteve që u bënë “rezistente ndaj ekinokandinave” që është ilaçi antimykotik më i rekomanduar për trajtimin e infeksionit.
CDC ia atribuon rritjen e numrit të rasteve të raportuara me parandalimin e dobët të infeksionit në institucionet e kujdesit shëndetësor, si dhe përpjekjet e zgjeruara të shqyrtimit që kanë rritur rritjen e infeksioneve, shkruan BBC.
Gjithashtu mund të jetë përkeqësuar për shkak të tendosjes në kujdesin shëndetësor dhe sistemet e shëndetit publik gjatë pandemisë Covid-19.
Në Misisipi, epidemiologu kryesor i shtetit ka identifikuar një strukturë afatgjatë të kujdesit akut që të jetë në qendër të shpërthimit.
“Fatkeqësisht, organizmat rezistent ndaj shumë ilaçeve si C. auris janë bërë më të përhapur në mesin e individëve tanë me rrezik më të lartë, siç janë banorët në objektet e kujdesit afatgjatë,” tha Dr Paul Byers për NBC.
Sipas të dhënave paraprake të CDC, kishte 5 raste klinike të Candida auris në vitin 2022. Në shtetet më të populluara si Kalifornia dhe Teksasi, kishte përkatësisht 359 dhe 160 raste.
Në mbarë vendin kishte 2,377 raste klinike në 2022, që do të ishte një rritje e dukshme nga 1,471 raste në 2021.
Dr Lyman, tha për CBS News se rritja “thekson nevojën për mbikëqyrje të vazhdueshme, kapacitet të zgjeruar laboratorik, teste më të shpejta diagnostikuese dhe respektimin e parandalimit dhe kontrollit të provuar të infeksionit”.
Vende të tjera gjithashtu kanë parë një rritje të rasteve të Candida auris.
Vitin e kaluar, Organizata Botërore e Shëndetësisë e përfshiu atë në listën e saj të “patogjenëve me përparësi fungale”.